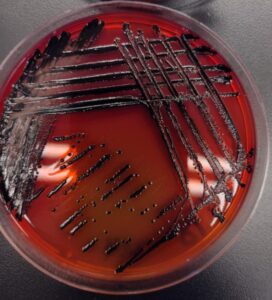

Desde la UC: Innovación biotecnológica para alimentos más seguros
7 de noviembre 2025
Integrantes de BaFoP Lab
Cada 3 de noviembre se celebra el Día Mundial de Una Salud, enfoque que reconoce la profunda interdependencia entre la salud humana, animal y ambiental. En esta línea, la UC ha asumido un papel activo en el diseño de proyectos orientados a abordar desafíos sanitarios globales. Entre estos destacan dos desarrollos tecnológicos orientados a fortalecer la inocuidad alimentaria.
Detener la transmisión de enfermedades entre especies, mejorar la inocuidad de los alimentos en toda la cadena alimentaria, y promover el uso responsable de antibióticos ante la resistencia a los antimicrobianos, son temas vinculados a la mirada Una Salud que diversos actores de la UC han venido trabajando desde hace años, buscando crear y articular equipos interdisciplinarios y multisectoriales.
En el caso de la inocuidad de los alimentos, garantizar que estos sean seguros es un desafío complejo, que implica controlar diversas condiciones para evitar variados riesgos biológicos, químicos y físicos, que pueden aparecer en cualquier etapa, desde el inicio hasta el momento en que llegan a la mesa.

Dra. Andrea Moreno en Encuentro del Día de Una Salud UC
Desde hace veinte años, la Dra. Andrea Moreno Switt, Directora de la Escuela de Medicina Veterinaria UC, ha orientado parte importante de su trabajo en el área de patógenos transmitidos por alimentos, especialmente Salmonella y Listeria monocytogenes.
Hoy, dirige el proyecto FONDEF I+D SalmoClean, una propuesta que busca controlar la presencia de Salmonella spp. en pabellones de crianza de pollo broiler. Además, a partir de sus investigaciones con bacteriófagos, creó la start-up Safe Foods. Mientras SalmoClean actúa al inicio de la cadena alimentaria -en la producción avícola-, Safe Foods se centra en el final del proceso.
Salmonella
SalmoClean: innovación desde el primer eslabón
La tecnología de esta iniciativa está basada en un ensamble de bacteriófagos con nanopartículas de cobre y biopolímeros que se aplica en bebederos, camas y guano de las aves en crecimiento. Es decir, la innovación se focaliza en los primeros eslabones de la cadena productiva.
Junto a su laboratorio BaFoP Lab, pensaron en utilizar fagos para reducir la Salmonella en esas superficies, pero era necesario protegerlos de factores hostiles, como la presencia de desinfectantes, la humedad y la materia orgánica, para que el compuesto activo –el bacteriófago- siguiera siendo viable.
“Ahí surgió la colaboración con la Decana de la Facultad de Ingeniería, la Dra. Loreto, quien trabaja con biopolímeros y con la empresa Nanotech Social Project. Después de varias reuniones, comenzamos a desarrollar esta idea: un cóctel de fagos dirigido a los serotipos de Salmonella, que podría aplicarse como una película protectora en el comedero y en el bebedero, o incluso como una tecnología de aspersión para las camas”, explica.
En el desarrollo de esta propuesta, la colaboración interdisciplinaria y la diversidad han sido elementos centrales, uniendo a la industria, Ingeniería y la Escuela de Enfermería, representada por la Dra. Diana Álvarez, veterinaria y profesora de esta unidad. Además de las tres académicas, integran el equipo una bioquímica, dos estudiantes de doctorado, un estudiante de bioquímica y otro de biología.
Safe Foods: transferencia de la innovación al mercado
En 2024, la Dra. Andrea Moreno lanzó Safe Foods, una spin-off reconocida por la UC, que nace de una necesidad concreta: que las innovaciones universitarias lleguen efectivamente al mercado. La empresa ofrece soluciones biotecnológicas para la inocuidad alimentaria, y hoy trabaja en PhageStop, uno de los proyectos ganadores del Concurso I+D para Innovar 2025 de la Fundación Copec-UC.
“Lo que proponemos con Safe Foods es una solución más sustentable: menos productos químicos, menos desinfectantes y una tecnología biológica de precisión basada en fagos que atacan Salmonella”, explica la Dra. Moreno.
Esta innovación se podría aplicar en carne de pollo, pavo o cerdo, y también en otras matrices alimentarias. Busca reducir la presencia de Salmonella, controlar bacterias que alteran la calidad del alimento y, al mismo tiempo, disminuir la aparición de superbacterias resistentes.
Mirada UC: integrar diversas disciplinas
Para la Dra. Moreno, la UC se ha convertido en un terreno fértil para el trabajo interdisciplinario y la innovación colaborativa, que favorece la posibilidad de entrecruzar visiones e imprime una riqueza creativa colectiva.
“Nunca antes había tenido un equipo tan interdisciplinario como el que tenemos ahora en la UC. Creo que esa es una de las grandes ventajas de ser una escuela vinculada a tres facultades fundantes. Además, el ecosistema del campus San Joaquín facilita esa interacción”.
Para ella, la innovación también significa formar nuevas generaciones con la visión más amplia y, de acuerdo con su experiencia, es visible que los actuales estudiantes cuentan con una mentalidad de transferencia y propósito. “Quieren que su ciencia tenga sentido, que sirva. Ese impulso es fundamental para fortalecer el ecosistema de investigación aplicada y emprendimiento científico en Chile”, concluye.





